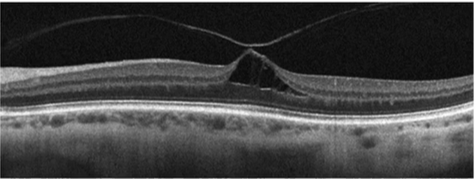
<p>Describe the pic </p>
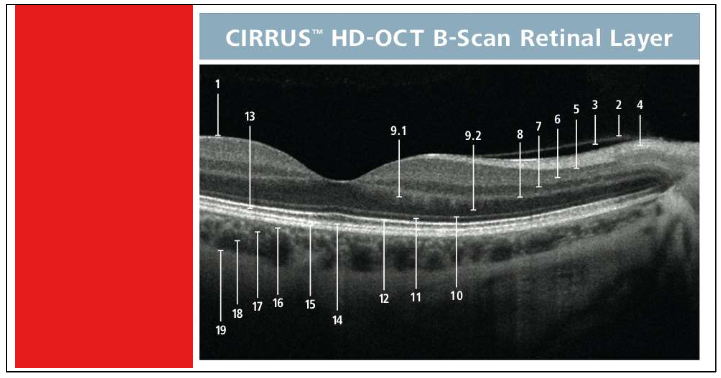
<p>Name the layers</p>
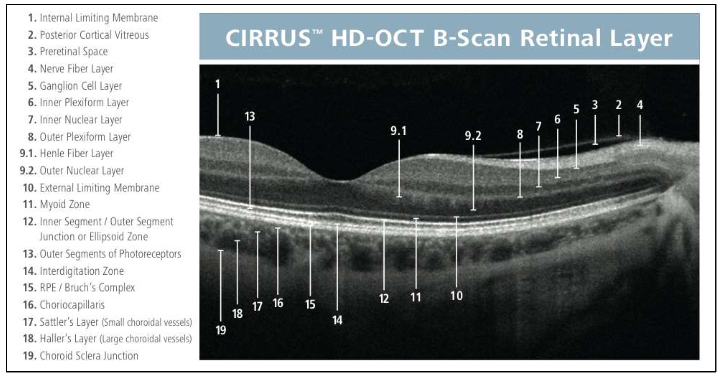
knowt flashcard image
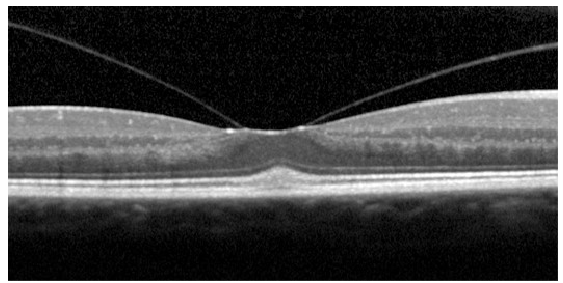
<p>Name the condition</p>

1/58
Looks like no tags are added yet.
Name | Mastery | Learn | Test | Matching | Spaced | Call with Kai |
|---|
No analytics yet
Send a link to your students to track their progress

What is this condition
All RD
2nd pic=Tractional
3rd pic=Exudative-pockets where the retina has come off, fluid under retina in the subretinal space
What are the types and causes of retinal detachment?
Rhegmatogenous Retinal Detachment (RRD)
Cause: retinal break
Tractional (TRD, retina pulled away by contracting vitreoretinal membranes eg ERM)
Causes: proliferative DR, retinopathy of prematurity, toxocariasis, trauma, previous giant retinal tear
Exudative (fluid derived from the choriocapillaries gains access to subretinal space)
Causes: neoplastic choroidal lesions, inflammatory disease, optic pit, choroidal coloboma, vascular disorders, nanophthalmos


What is this condition?
Rhegmatogenous Retinal Detachment
Colours appear to change/lose focus can’t see vessels as clearly

Name the condition
Retinal Tear/ Hole RRD
Retinal tear/hole RRD
Risk factors
Pathophysiology
Risk Factors
Lattice degeneration
High myopia/ structural change in axial length
Prev HST/ RD
Aphakia
Pseudophakia
Age-related retinoschisis
Trauma
Hereditary disorders
Stickler’s Syndrome
Marfan’s Syndrome
Pathophysiology
PVD- HST
Traction, sub retinal fluid
Tissue weakness, partic true in genetic conditions

Name the condition
Retinoschisis
Splitting of retina in any area-central/periphery may not be across the entire
What are the types of retinoschisis and management?
Juvenile X linked retinoschisis
Foveal schisis: cystoid spaces with a “bicycle-wheel” pattern of radial striae
Peripheral schisis
Vitreous haemorrhage
Age-related retinoschisis
Immobile dome shaped elevation of the retina typically inferotemporally
IT in older retinas
May progress circumferentially
High myopia
Management
Retinal examination with sclera indentation to exclude retinal break
A fundus contact lens evaluation
Gonio lens to see up to ora serrata
No treatment for foveal schisis (stellate maculopathy)
Surgical repair of RD
What is diabetic retinopathy and its classifications?
Preventable Cause of Blindness
Several Classifications
Background
Pre-proliferative
Proliferative
Maculopathy
Rubeosis
Affects aq humour outflow →ACG or OAG
Can all affect VA,VF,colour vision,CS
Can lead to early cataract

Name this condition
Proliferative DR
Proliferative DR
Clinical signs
Fluorescein angiography
Treatment
Clinical signs
NVD, NVE, NVI
Fibrovascular tissue along the posterior surface of the vitreous
Fibrovascular tissue extending into the vitreous and adherent to the retina
Traction retinal detachment
Vitreous haemorrhage
Fluorescein angiograpy
Highlights the neovascularisation
Hyperfluorescence due to leakage from neovascular tissue
Treatment
PRP
Surgical treatment of retinal detachment
Pars plana vitrectomy in vitreous haemorrhage
Anti VEGF treatment with caution
Follow up every 4 weeks 7


Name this condition
Diabetic maculopathy And DME
1st pic=Dot-blot haems + exudates
2nd pic=OCT=Cystic spaces ,vitreous has alr come off
3rd pic=Wide field FA, various areas w/ hyperfluorescence where leakage present
Diabetic maculopathy And DME
Clinical signs
Fluorescein angiography
Treatment
Clinical signs
May be present and include signs of any of the stages listed
Well-circumscribed or diffuse retinal thickening
Complete or incomplete rings of perifoveal hard exudates
Dark-blot haemorrhages
Fluorescein angiography
Ischemic-capillary non-perfusion at the fovea
Diffuse exudative – late diffuse hypefluorescence due to leakage
Focal exudative – focal hyperfluorescence, good macular perfusion
Treatment
Focal/ Grid Laser if clinically significant macular oedema (CSMO)
Anti-VEGF
Periocualr/ intravitreal steroid

Name the condition
Retinal Vein Occlusions- CRVO, BRVO, Hemi-retinal Vein Occlusion

Describe the picture
BRVO
Only ½ of retina affected-macula affected
Depending on which venous branch is affected through the occlusion macula may be spared

Describe the picture
HRVO
CWS + haemorrhaging

Name the condition
CRVO
More flame shaped hems-w/in NFL layer (arcuate shape of nerve fibres across the retina)
Retinal Vein Occlusions- CRVO, BRVO, Hemi-retinal Vein Occlusion
Acute features
Late features
Classification
Painless loss of vision
Acute features
Diffuse retinal haemorrhages
Dilated tortuous retinal veins
Cotton-wool spots
Optic disc oedema
Macular oedema
Late features
Collateral venous channels
Hard exudates, Microaneurysms
NVE, NVD
NVI, Rubeotic glaucoma
Fibrous proliferation
→tractional RD
Classification
BRVO
CRVO
Entire retina affected
Hemi retinal Vein Occlusion
½ of retina affected

Name the condition
Central Retinal Artery Occlusions
Pale fundus with cherry red spot

Name the condition
Branch of central retinal artery affected
Low contrast area

Name the condition
Cherry red spot in the retina
Retinal Artery Occlusions
Symptoms
Clinical signs
Causes
Symptoms
Painless, abrupt loss of vision (central retinal artery occlusion -CRAO) or partial visual field (branch retinal artery occlusion-BRAO) within seconds
Clinical signs
Superficial opacification or whitening of the retina
Cherry-red spot in the centre of the macula (in CRAO)
Narrowed retinal arterioles
Cotton-wool spots (in BRAO)
Afferent pupillary defect
Retinal arteriolar emboli
esp if BRAO
Causes
Embolus
Thrombosis
Giant cell arteritis
Other collagen-vascular diseases
Hypercoagulation disorders
Carotid dissection
Trauma
Ask about cardiovascular conditions e.g prev thrombosis in other body parts, or diagnosed with carotid artery stenosis -build up of abnormal tissue could break loose

Name the condition
Sickle Cell Retinopathy
Sickle Cell Retinopathy
Non proliferative retinopathy
Clinical signs
Proliferative retinopathy
Clinical signs
Management
Non proliferative retinopathy
Clinical signs
Tortuous veins
Silver-wiring of arterioles in the peripheral retina
Salmon patches-pink pre retinal haemorrhages
Black sunbursts-hyper pigmentation due to RPE hypertrophy
Proliferative retinopathy
Clinical signs
Stage 1: peripheral arteriolar occlusion
Stage 2: Peripheral arteriovenous anastomoses
Stage 3: New vessels from the anastomoses (“sea- fan” configuration)
Stage 4: Vitreous haemorrhage
Stage5: Fibrovascular proliferation and tractional RD
Management
Control underlying disease
Laser treatment of neovascularisation

Name the condition
Retinal artery macroaneurysm
Some visual function can’t be recovered
Retinal artery macroaneurysm
Clinical findings
Work up
Treatment
Clinical Findings
“Hemorrhage in all three layers”
Sub retinal
Intra retinal
Pre-retinal
Aneurysmal area over vessel, usually white
Work-up
Hypertension
Cerebrovascular syndrome
Treatment
Argon
Yag

Name the condition
Macular holes
Top one=Still some intact macula tissue
2=Laminar hole
3=Operculum pulled off
4=Parting until bruch’s membrane
Describe the pic
Macular hole
OCT cross section
Vitreous come off but the macula is pulling/still attached
Large cystic space underneath
Pt complaining of reduced central vision/blurriness
Older pt-May need to inc add/ varis

Describe the pic
Macular hole
Macular Holes
Symptoms
Clinical signs
Management
Symptoms
Decreased vision
Central visual field defect
Clinical signs
Early stage of macular hole – loss of foveolar depression and yellow spot in the centre of the macula
Late stage of macular hole- a round red lesion in the centre of the macula surrounded by a halo
Management
Treatment not required in 50% (resolves spontaneously)
Vitrectomy
ILM peel
Intraocular gas tamponade, posture
Follow up every 6-12 months
Retinal detachments and holes
Basic retinal anatomy
Individual retinal layers
2 blood circulations (retinal and choroidal circulation)
Helps to identify type of hole → link with appearance
Name the layers

Label the eye

Retinal detachment and holes
Vitreo-retinal anatomy
98 % Water
Strongly adherent to retina at vitreous base, optic disc and along major vessels arcades
Danger if there’s a pull → bleeding into vitreous space/pre retinal space causing severe haemorrhaging
Type II collagen t½ 40yr
Type IX collagen t½ 11yr
→ clumping/reduction in vitreous size
Name the condition
Retinal detachment and holes
Vitro-macular traction Note: while this looks very serious, this is only “traction” and does not warrant referral.
The patient is most likely not aware of it
Vitreous has come off on either side of the macula but it’s pulling the macula up, only classed as traction- wouldn’t refer at this point, not much effect on VA
What is the grading scale by Gass based on?
Biomicroscopy findings + their clinical interpretations.
Since the introduction of OCT, other authors have worked on improving clinical interpretation by using OCT images
Retinal detachment and holes
Classification scale
Stage
Biomicroscopy (Gass)
Interpretation (Gass)
OCT
Stage 0 (MH):
Perifoveolar posterior hyaloid detachment with normal fovea or minor contour changes
Stage 1A (Impending MH):
Central yellow spot, loss of foveolar depression, no vitreofoveal separation
Early serous foveolar detachment
OCT: perifoveolar hyaloid detachment + foveal cyst
Stage 1B (Impending MH):
Yellow ring with bridging interface, loss of foveolar depression
Serous detachment or occult hole with bridging prefoveolar cortex
OCT: cyst extends into outer retina (“occult macular hole”)
Stage 2 (Full-thickness MH):
Small eccentric/oval or crescent defect within yellow ring
Vitreous still attached (no full PVD)
May have pseudo-operculum
Stage 3 (MH):
Central round defect ≥400 µm with elevated rim
No Weiss ring (no complete PVD)
Partial vitreous detachment
Stage 4 (MH):
Full-thickness hole with complete posterior vitreous detachment
Weiss ring present
Posterior hyaloid no longer visible on OCT
Key concepts:
Progression from foveal cyst → full-thickness hole
Increasing vitreous separation and traction changes across stages


Stages of a macula hole
Stage 1: Vitreous has come off in parts + little bit of pull
Stage 1A=Some tractional change + cystic spaces
More traction + tissue removed
No foveolar→ tissue has been pulled away (part of it) no stability in that region anymore


Posterior Vitreous Detachment
Who is affected
Symptoms
Development and clinical signs
Who is affected?
Typically people in their 50-60s
Can occur earlier in life especially in high myopes
Symptoms?
Blurry vision, flashes and floaters
Development and clinical signs?
Syneresis of vitreous
Pockets of syneretic fluid
Posterior hylaloid “breakthrough”
Weiss Ring
Haem/ Tobacco dust consider HST
Note the Weiss Ring which is in focus, compared to the blurry (not focussed) ONH: this indicates that both are not at the same depth....i.e. the vitreous has detached from the retina


Name the condition
CSR
Central Serous Chorioretinopathy- CSCR/CSR
Symptoms
Clinical signs
Investigations
Management
Symptoms
Decreased, blurred vision
Metamorphopsia
Central defect in the visual field
Colours appears washed-out
Clinical signs
Usually unilateral sometimes bilat
Localised elevation of the retina in the macular region
Focal hyperpigmentation (sign of previous episodes)
Investigations
Fluorescein angiography (“smoke- stack” , “ink-blot” leakage)
Neovasc
Management
Usually not required (most cases [~80%] recover in ~6-9months)
Laser treatment may be considered
![<ul><li><p>Symptoms</p><ul><li><p>Decreased, blurred vision</p></li><li><p>Metamorphopsia</p></li><li><p>Central defect in the visual field</p></li><li><p>Colours appears washed-out</p></li></ul></li><li><p>Clinical signs</p><ul><li><p>Usually unilateral sometimes bilat</p></li><li><p>Localised elevation of the retina in the macular region</p></li><li><p>Focal hyperpigmentation (sign of previous episodes)</p></li></ul></li><li><p>Investigations</p><ul><li><p>Fluorescein angiography (“smoke- stack” , “ink-blot” leakage)</p><ul><li><p>Neovasc </p></li></ul></li></ul></li><li><p>Management</p><ul><li><p>Usually not required (most cases [~80%] recover in ~6-9months)</p></li><li><p>Laser treatment may be considered</p></li></ul></li></ul><p></p>](https://assets.knowt.com/user-attachments/d59c9663-67ae-4c71-a4a8-6fe5a9fd4843.png)

Name the condition
ERM
More visible with red free
Epiretinal Membrane- ERM Macular Pucker
Symptoms
Causes
Clinical signs
Symptoms
Largely asymptomatic
May present with decreased and distorted vision (glare)
Changes over time-memb is contractile-metamorphopisa at diff levels
Often bilat
Causes
Idiopathic
Retinal break
Retinal detachment
Laser photocoagulation
Ocular surgery
Trauma
Intraocular inflammation
Diabetic retinopathy
Other retinal vascular diseases
Clinical signs
Glistering membrane (cellophane maculopathy)
Thick grey membrane (macular pucker)
Retinal folds
Management
Membrane peeling =more common in Germany than UK
risks=not done freq


Name this condition
Angioid streaks
Angioid streaks
Bilateral crack-like reddish bands usually radiating in a spoke-like pattern
Causes
Pseudoxantoma elasticum
Paget disease
Sickle cell disease
Ehler-Danlos
Acromegaly
Marfan syndrome
Lead poisoning
Senile elastosis
Complications
CNVM
Choroidal haemorrhage
Depending on the location of the streaks they can affect the macula
impact visual function signif
Foveal involvement by extended streak
Management
Treat underlying condition
Follow up every 6 months
Treat CNV by laser photocoagulation
Some ocular conditions contain collagen, genetic conditions affects collagen in terms of elasticity and tensile strength

Name the condition
Retinitis Pigmentosa

Retinitis Pigmentosa
Inheritance pattern
Symptoms
Clinical signs
Investigations
Inheritance pattern:
Autosomal dominant (common, the best prognosis)
Autosomal recessive (less common, intermediate prognosis)
X linked (least common, most severe)
Affects males more (XY), women can be carriers (2 X chromosomes)
Symptoms
Night blindness and loss of peripheral vision
Late symptoms: poor central and colour vision
Clinical signs
“bone spicule” retinal pigmentary changes starting from midperiphery and gradually extending anteriorly and posteriorly
Areas of depigmentation (RPE atrophy)
Narrowing of arterioles
Optic disc atrophy
Investigations
VF testing
Electroretinography
Fundus photography
Retinitis Pigmentosa
Management
Exclude systemic associations:
Bassen-Kornzweig syndrome (deficiency in beta-lipoprotein)
Refsum disease (deficiency in the enzyme phytanic acid 2- hydroxylase)
Usher syndrome (combined deafness and RP)
Kearns- Sayre (mitochondrial cytopathy)-refer to cardiologist (danger of complete heart block)
Bardet-Biedl syndrome (mental handicap, polydactily, obesity, hypogenitalism, RP)
No definitive treatment for RP: gene editing/ stem cell treatment ongoing trials with promising results (not all approved yet)
Artificial retinal implants, show promise
Can send signals to retina to create some light perception→ can improve ability to read


Name the condition
Stargardt’s Disease Fundus Flavimaculatus
Stargardt’s Disease Fundus Flavimaculatus
Symptoms
Clinical findings
Symptoms:
Bilateral decrease of vision in childhood, early adulthood
Clinical findings:
Heavily pigmented RPE in the macula (early stage)
Yellow –white with fleck like deposits in the macular
Atrophic macular degeneration.
Dark FFA appearance
No treatment
Stem cell treatment, gene editing ??poss

Name the condition
Stickler’s syndrome
Pigmentary changes-tissue ,breaks,migration of RPE
Neovasc changes
What are the key features of Stickler’s syndrome?
Autosomal dominant
Collagenopathy
Type 2 and Type 11
Characteristic faces
Flat faces/changes to ocular bones/present w/ hearing loss or joint problems/under developed bones in the middle of the face-cheek + nose
Implications when prescribing lenses/ bridge design
Ophthalmology
Myopia
Paediatric cataract
Lattice - radial
RD
Glaucoma


Name the condition
Best’s Disease- Vitelliform maculopathy
Pigmentary changes-yellow/white-more where RPE/NFL loss -more light reflecting back from choroidal circulation
Best’s Disease- Vitelliform maculopathy
Symptoms
Clinical findings
Complications
Symptoms
May be asymptomatic or present with decreased vision
Clinical findings
Yellow, round, subretinal lesion in the macula (“egg yolk”) or pseudo hypopyon
EOG
Assess level of visual function
Complications
Macular CNV
Haemorrhage
Scarring

Name the condition
Familial dominant drusen
What are the key features of Familial dominant drusen?
Autosomal dominant
Multiple drusen
Scattered rather than concentrated in macula area
Usually symptom free but may develop symptoms similar to AMD later on in life (i.e. may develop AMD)
Younger pts (i.e. younger than your typical AMD patient)
30’s or younger
No treatment
Explain there could be a change in symptoms with aging

Name the condition
Drug induced retinopathies
Agents may bind to melanin in RPE
Could lead to a concentration of drugs + prolong their adverse effects
Duration of drug taken/dosage/
What are the main drug-induced retinopathies and their associated medications?
Antimalarials (chloroquine) → bull’s eye maculopathy
Phenothiazines (thioridazine, chlorpromazine)
Toxic crystalline maculopathies (tamoxifen, canthaxanthin, methoxyflurane)
What is the optometrist’s role in managing patients with lifelong ocular conditions?
Conditions have lifelong impact on vision and daily life
Role includes managing stable conditions, providing support, low vision aids, and referrals as conditions progress
Excellent communication is essential for information, empathy, and managing expectations
What are the key considerations when assessing and differentiating ocular conditions over time?
Conditions can affect visual function throughout life (early, stable, or progressive)
Increased risk of further abnormalities or earlier age-related changes (e.g. cataract)
Similar presentations (e.g. AMD vs familial dominant drusen) → cannot rely on appearance alone; consider age, family history, and visual function